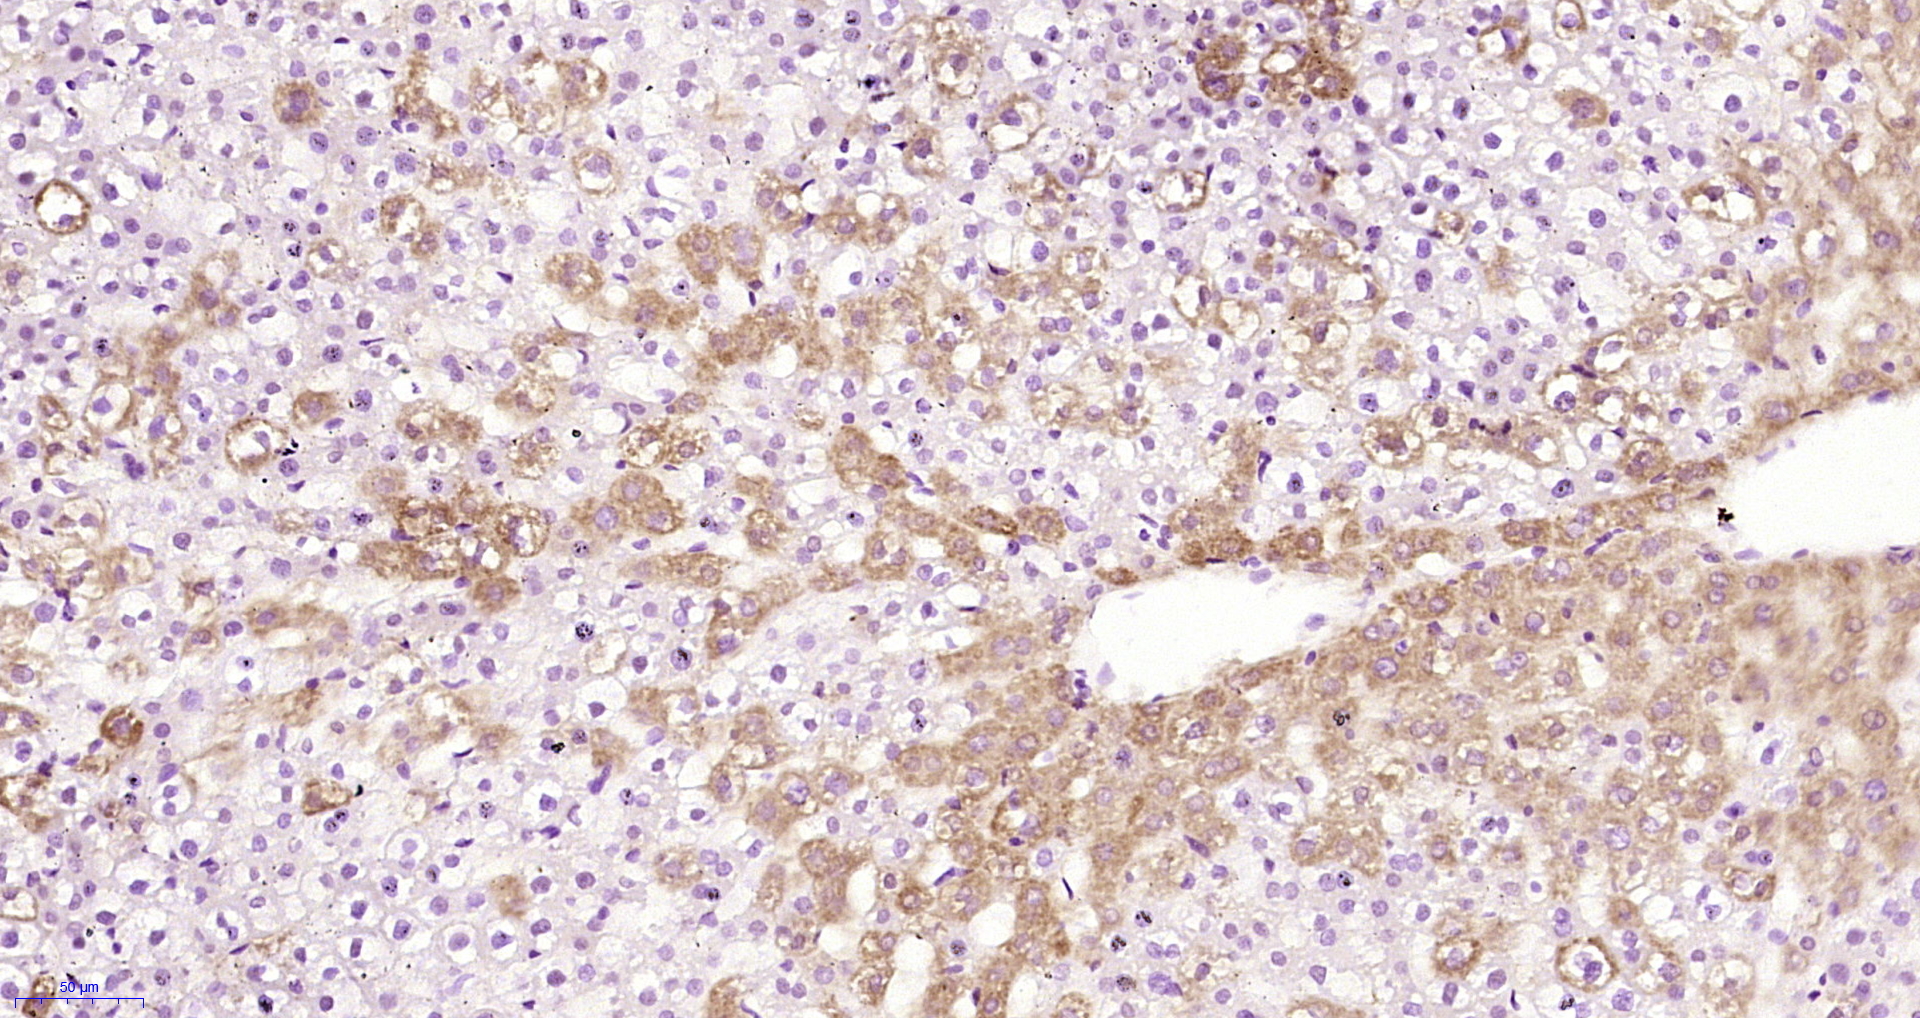

Lane 1: Liver lysates probed with Alpha 2 antiplasmin Polyclonal Antibody, Unconjugated (bs-6188R) at 1:1000 dilution and 4˚C overnight incubation. Followed by conjugated secondary antibody incubation at 1:20000 for 60 min at 37˚C.
Alpha 2 antiplasmin Polyclonal Antibody
bs-6188R
ApplicationsImmunoFluorescence, Western Blot, ELISA, ImmunoCytoChemistry, ImmunoHistoChemistry, ImmunoHistoChemistry Frozen, ImmunoHistoChemistry Paraffin
Product group Antibodies
ReactivityCanine, Equine, Human, Mouse, Rabbit, Rat
TargetSERPINF2
Overview
- SupplierBioss
- Product NameAlpha 2 antiplasmin Polyclonal Antibody
- Delivery Days Customer16
- ApplicationsImmunoFluorescence, Western Blot, ELISA, ImmunoCytoChemistry, ImmunoHistoChemistry, ImmunoHistoChemistry Frozen, ImmunoHistoChemistry Paraffin
- Applications SupplierWB(1:300-5000), ELISA(1:500-1000), IHC-P(1:200-400), IHC-F(1:100-500), IF(IHC-P)(1:50-200), IF(IHC-F)(1:50-200), IF(ICC)(1:50-200)
- CertificationResearch Use Only
- ClonalityPolyclonal
- Concentration1 ug/ul
- ConjugateUnconjugated
- Gene ID5345
- Target nameSERPINF2
- Target descriptionserpin family F member 2
- Target synonymsA2AP, AAP, ALPHA-2-PI, API, PLI, alpha2AP, alpha-2-antiplasmin, alpha-2-AP, alpha-2-plasmin inhibitor, plasmin inhibitor, serine (or cysteine) proteinase inhibitor, clade F (alpha-2 antiplasmin, pigment epithelium derived factor), member 2, serpin F2, serpin peptidase inhibitor, clade F (alpha-2 antiplasmin, pigment epithelium derived factor), member 2
- HostRabbit
- IsotypeIgG
- Protein IDP08697
- Protein NameAlpha-2-antiplasmin
- ReactivityCanine, Equine, Human, Mouse, Rabbit, Rat
- Storage Instruction-20°C
- UNSPSC12352203
References
- Schmal O, Seifert J, Schäffer TE, et al. Hematopoietic Stem and Progenitor Cell Expansion in Contact with Mesenchymal Stromal Cells in a Hanging Drop Model Uncovers Disadvantages of 3D Culture. Stem Cells Int. 2016,2016:4148093. doi: 10.1155/2016/4148093Read this paper